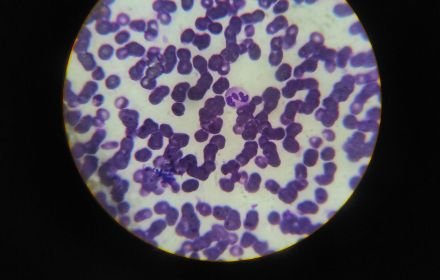

PLPC-DB™ de Programa Oncovix: La plataforma avanzada de inmunoterapia estructural que busca reparar la respuesta contra el cáncer, de distinto tipo y en cada etapa.
Patrocinado Salud Por más de 11 años, el equipo de OGRD Alliance liderado por el oncopatólogo Dr. Ramón Gutiérrez-Sandoval, han desarrollado una innovadora línea de inmunoterapias derivadas de células dendríticas humanas. El resultado actual de este trabajo es la plataforma PLPC-DB™ (Complejo Fosfolipoproteico Ultrapurificado – Bioendógeno Dendrítico), incorporada al Programa Oncovix. ¿Qué es exactamente PLPC-DB™? […]